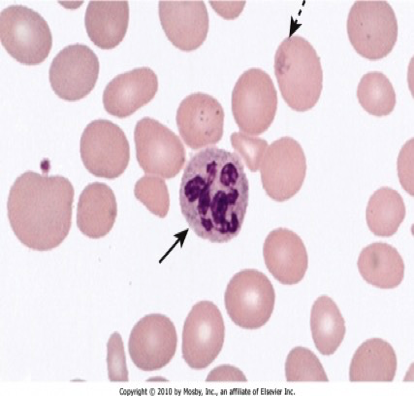

PERNICIOUS ANEMIA
It is an autoimmune disorder in which antibodies are formed against the parietal cells of the stomach & against intrinsic factor, resulting in loss of “intrinsic factor” production. This then causes Vit.B12 deficiency, which then produces a megaloblastic anemia.
OTHER CAUSES OF VIT.B12 DEFICIENCY ARE NOT CALLED PERNICIOUS ANEMIA. THEY ARE JUST CALLED MEGALOBLASTIC ANEMIA DUE TO VIT. B12 DEFICIENCY
- A common cause of B12 deficiency in the West
- More common in old people
- Associated with other autoimmune diseases: * Autoimmune thyroiditis * Vitiligo * Addison’s disease * DM
- Most patients have “parietal cell antibodies” & “intrinsic factor antibodies.” (more specific)
S/S
of Vit B12 deficiency develop slowly over few yrs., because, as said before, liver has enough amounts of B12 which can last for more than 2 yrs.
S/S OF PERNICIOUS ANEMIA

Anemia S/S
- all anemias cause this
Pallor, tachycardia, systolic murmur
weakness, fatigue |
- Glossitis (tongue inflammation)
NEUROLOGICAL S/S OF B12 DEFICIENCY
- Peripheral Nerves
- Spinal cord
- Brain
- Peripheral neuropathy:
- Tingling & numbness in the toes & fingers (symmetrical)
- Subacute combined degeneration of the cord
- There is damage to the posterior column & lateral white column of the spinal cord. This leads to Imbalance of:
a) Loss of position & vibration sense
b) Weakness
c) Ataxia
- Brain: dementia, psychiatric problems If neuro features are present for less than 6 months, they can be corrected NOTE: Neuro features can occur even without anemia & with a normal CBC
INVESTIGATIONS IN PERNICIOUS ANEMIA
- CBC
- Low Hb
- MCV high (due to macrocytes)
- May be low WBC & plts. (late)
-
Peripheral Smear:
- Macrocytes; in bone marrow
- Large abnormal neutrophils with hypersegmented nucleus (multilobed nucleus)
(Note the large RBCs & the large neutrophil with multilobed nucleus)
(Note the large RBCs & the large neutrophil with multilobed nucleus)
-
Low Vit.B12 levels in the blood
-
In some cases of borderline B12 levels, check MMA (methylmalonic acid). It is high
-
Serum autoantibodies:
- Intrinsic factor ab.
- Parietal cell ab. (if B12 deficiency is due to other causes, these antibodies will not be present)
-
Bone Marrow:
- Megaloblasts (large cells with immature nucleus)
- Frequently not done in a straightforward case of macrocytic anemia with low B12 levels.

So, specific diagnostic tests for pernicious anemia are:
a) Parietal cell antibodies
b) Intrinsic factor antibodies
D/D of Pernicious Anemia
- Folic acid deficiency
- Drug induced megaloblastic anemia
TREATMENT OF P.A.
-
i.m. injections of B12: Different protocols are used:
- 1mg i.m. daily for 1 wk
- Then, 1mg once a wk. for 1 month
- Then 1 mg once a month “forever” JUST REMEMBER THAT TREATMENT IS BY I.M. INJECTIONS & IT IS FOREVER
-
High doses of oral B12 can be used (absorption by alternate pathway, not requiring intrinsic factor). However, this is not preferable.
B12 deficiency causes folic acid def. also. So, for a few months, give folic acid also alongwith B12
Treatment contd.
- Anemia is corrected in few weeks, but mild neuro S/S improve in 6-12 months
- Full blown neuro features are irreversible
Stomach cancer risk
Patients with pernicious anemia have an increased risk of gastric carcinoma. So they should be regularly screened for this, by endoscopy or barium studies.